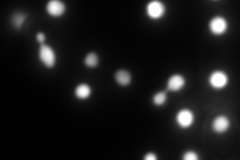
YPR052C
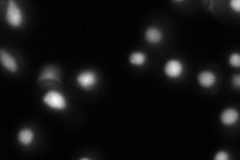
YPR052C

View description
High-mobility group non-histone chromatin protein, functionally redundant with Nhp6Bp; homologous to mammalian high mobility group proteins 1 and 2; acts to recruit transcription factor Rcs1p to certain promoters
Localization:
Intensity:
Fold change:
Significance:
-
C’ GFP library in SD

nucleus153.88 -
N' NOP1pr-GFP in SD

nucleus310.96 -
N' TEF2pr-mCherry in SD
nucleus517.215 -
N' NATIVEpr-GFP in SD
nucleus137.603 -
N' TEF2pr-VC and Cyto-VN in SD

nucleus78.5677 -
C’ GFP library in SD+DTT

nucleus179.511.16No -
C’ GFP library in SD+H2O2

nucleus111.20.72No -
C’ GFP library in Starvation Media

nucleus126.010.81No -
C’ GFP library on the background of Pup2-DaMP

N/A -
C’ GFP library on the background of CCT mutant

N/A0N/AYes
